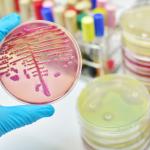

ООН прие първия договор за защита на екосистемите в открито море
Държавите, членуващи в ООН, приеха първия международен договор за защита на открито море, който е много важен за опазване на океаните, съобщи АФП.
"Договорът е приет", обяви под общи аплодисменти Рена Лий, председателката на междуправителствената конференция за морско биоразнообразие в районите извън национални юрисдикции, след като договорът беше приет с консенсус.
"Океанът е жизнената сила на нашата планета. Днес Вие вдъхнахте нов живот и нова надежда, че той има шанс да се бори", коментира генералният секретар на ООН Антониу Гутериш и приветства "историческия успех".
Въпреки приемането на договора, Русия се дистанцира от консенсуса, като определи някои елементи от текста като "напълно неприемливи", пише БТА. Първият договор за защита на екосистемите в открито море, приет днес, дава инструменти и възможности за опазване и устойчиво управление на морското биоразнообразие в огромните океански пространства, които не принадлежат на никого.
Документът, чието парафиране от страните на ООН ще започне на 20 септември, ще влезе в сила 120 дни след 60-ата му ратификация.
Основната цел е "незабавно и дългосрочно" опазване и устойчиво използване на морското биоразнообразие в зони извън национална юрисдикция. Това е огромна територия, която представлява почти половината от планетата ни.
Договорът ще се прилага за открито море, т.е. за частта от океаните извън изключителните икономически зони на държавите, които се простират на максимум 200 морски мили (370 км) от брега. Той ще обхване и морското дъно и земните недра извън националните юрисдикции, наричани "зоната".
За прилагането му бъдещата конференция на страните участнички (КОП), ще трябва да работи с глобални и регионални организации, които сега имат правомощия върху части от океана.
Емблематичният инструмент на новия договор ще бъдат морските защитени зони, които сега съществуват предимно в териториалните води.
На базата на научни данни, по предложение на една или повече държави, ще може да се създават подобни територии в райони, които са уникални, особено за уязвими или важни застрашени видове.
Решенията като цяло ще се вземат с консенсус. Предвидено е обаче и важно изключение, за да се предотврати възможността дадена страна да блокира създаването на морска зона: ако консенсус не е възможен, то решение може да бъде взето с мнозинство от три четвърти.
В договора не се уточнява как ще се гарантира, че мерките за защита действително се прилагат в обширнитe райони, отдалечени от сушата. Някои експерти разчитат на сателити за наблюдение и установяване на нарушенията.
Всяка държава носи отговорност за действията, които са под нейна юрисдикция, дори и в открито море, например на кораб, плаващ под неин флаг.
Страна, независимо дали е морска, или не, както и всеки субект под нейна юрисдикция, ще може да събира растения, животни или микроби в открито море, чийто генетичен материал може да бъде използван, включително и с търговска цел, например от фармацевтични компании.
За да се гарантира, че развиващите се страни, които не разполагат със средства за финансиране на подобни скъпи изследвания, няма да бъдат лишени от това, което не принадлежи на никого, в договора е заложен принципът на "справедливо и равноправно разпределение на ползите", свързани с морските ресурси.
Текстът предвижда споделяне на научни ресурси (проби, генетични данни в рамките на "платформа за свободен достъп", трансфер на технологии към развиващите се страни и т.н.), както и финансови ползи, свързани с тях.
Преди да разрешат дадена дейност в открито море, извършвана под техен контрол, държавите първо ще трябва да проучат потенциалните последици за морската среда. Те трябва да публикуват редовно оценка на въздействието. Предвижда се също възможност за оспорване на разрешение за определена дейност, ако се появят непредвидени отрицателни влияния.